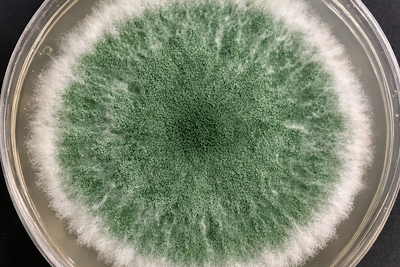
Trichoderma for plants: the Fungi that protect your roots

Your finger on the pulse of the agricultural bioproducts industry
Bassyana is a platform for learning about the latest trends in the biostimulants industry.
Latest Articles
#Bioinculants
Trichoderma for plants: the Fungi that protect your roots
Trichoderma is one of the most effective biological tools for root protection. Learn how it works, what pathogens it targets, and how to apply it properly in your crops.

#Biostimulants
Biologicals are not chemicals — And that’s the first thing we need to understand
Biologicals are not chemicals. They are living organisms in a living system. Learn why results vary, why patience matters, and how to use them properly.

#Biostimulants
The Biological Revolution: Why farmers are making the switch
Soil degradation, pest resistance, and stricter regulations are pushing farmers toward biologicals. Learn what's driving the shift and how to be part of it.

#Biostimulants
Why your Bioinoculant never actually worked (even though you thought it did)?
Bioinoculants often fail due to poor application timing, wrong conditions, or chemical incompatibility. Learn the five possible reasons yours didn't work and how to fix them.

#Biostimulants
Biostimulants 101: What they are and why your crops need them
Biostimulants explained: what they are, how they work, and when to apply them. A clear, no-jargon guide for farmers and professionals exploring biological agriculture.